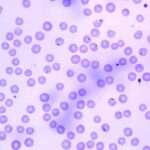
Ehrlichiosis y Anaplasmosis

El pox rickettsial es una enfermedad febril aguda, autolimitada, causada por Rickettsia akari, un parásito de los ratones. Esta enfermedad es transmitida por el ácaro Liponyssoides sanguineus, un ectoparásito que infesta a estos roedores. Rickettsia akari pertenece al grupo de las rickettsias conocidas como spotted fever, o fiebre manchada, y sus infecciones son reportadas a nivel mundial. En estudios de seroprevalencia realizados en personas que consumen drogas por vía intravenosa en Baltimore, se ha observado una tasa de seropositividad de hasta un 16%. En Nueva York, la enfermedad muestra una asociación estrecha con la pobreza, y también se ha documentado en comunidades rurales o en áreas de agricultura. Las condiciones de hacinamiento y viviendas infestadas de ratones favorecen la transmisión del patógeno a los humanos.
Manifestaciones clínicas
Desde el punto de vista clínico, la rickettsiosis por Rickettsia akari se caracteriza por la clásica tríada de fiebre, erupción cutánea y escara, manifestándose en aproximadamente el 99% de los casos. El síntoma inicial es la aparición de una pápula roja, indolora, que suele aparecer entre 3 y 10 días después de la picadura del ácaro, aunque el promedio de aparición es de una semana. Esta pápula evoluciona hacia una vesícula, que luego se ulcerará y se convertirá en una escara negra, la cual es uno de los signos distintivos de la enfermedad. La escara se forma en el sitio de la picadura y es un indicio claro de la infección. Aunque las lesiones de la fiebre de la picadura de garrapata africana, causadas por Rickettsia africae, pueden parecerse a las de la rickettsiosis por Rickettsia akari, existen diferencias clínicas importantes que permiten el diagnóstico diferencial.
La naturaleza autolimitada de la enfermedad implica que, en la mayoría de los casos, los síntomas mejoran sin tratamiento específico, aunque la intervención temprana con antibióticos puede ser beneficiosa para reducir la duración y severidad de la enfermedad. Las personas más vulnerables, como aquellas que viven en condiciones de hacinamiento o en contacto frecuente con roedores, tienen mayor riesgo de infección. La enfermedad también puede manifestarse en brotes, especialmente en áreas donde los roedores son comunes y el control de los vectores es deficiente.
El inicio de los síntomas de la rickettsiosis por Rickettsia akari es súbito y suele manifestarse con un cuadro clínico que incluye escalofríos, fiebre, cefalea, fotofobia y dolores musculares generalizados. La fiebre, que es uno de los síntomas predominantes, puede ir acompañada de una erupción papular que aparece entre 2 y 4 días después del inicio de la fiebre, con un promedio de entre 30 y 40 lesiones. Sin embargo, estas lesiones tienden a respetar las palmas de las manos y las plantas de los pies, lo que es un patrón característico de esta enfermedad. Las primeras lesiones son típicamente papulares y pueden parecerse a las vesículas que se observan en la varicela, aunque en el caso de la rickettsiosis por Rickettsia akari, las lesiones son generalmente papulovesiculares, mientras que en la varicela son predominantemente vesiculares. A medida que la enfermedad progresa, las lesiones vesiculadas evolucionan hacia costras en un periodo aproximado de 10 días.
A nivel patológico, las lesiones cutáneas de la rickettsiosis muestran signos evidentes de edema dérmico y vesículas subepidérmicas. La inflamación de los vasos sanguíneos a nivel dérmico parece ser una respuesta inflamatoria fundamental, caracterizada por vasculitis linfocítica y granulocítica. Este proceso inflamatorio es crucial para entender la distribución y aparición de las lesiones cutáneas y la evolución del cuadro clínico.
Exámenes diagnósticos
Desde el punto de vista diagnóstico, se ha identificado una proteína de membrana externa de 44 kDa que sirve como biomarcador de Rickettsia akari, lo cual facilita el diagnóstico de la enfermedad. Además, en el contexto clínico, pueden presentarse alteraciones hematológicas, como leucopenia transitoria (disminución del número de leucocitos) y trombocitopenia (bajo número de plaquetas), así como hepatitis aguda en algunos casos, lo que contribuye a la diversidad clínica de la rickettsiosis. Un aumento cuádruple en los títulos de anticuerpos séricos contra los antígenos rickettsiales, detectados mediante pruebas de fijación del complemento o ensayos indirectos de fluorescencia, es diagnóstico. Además, la inmunoglobulina anti-rickettsial conjugada puede utilizarse para identificar los antígenos en biopsias por punción de las lesiones cutáneas. La detección de ADN de Rickettsia akari mediante PCR en tejidos frescos también ha demostrado ser una herramienta valiosa para el diagnóstico.
Tratamiento
El tratamiento de la rickettsiosis por Rickettsia akari se basa en el uso de doxiciclina oral, administrada en una dosis inicial de 200 mg, seguida de 100 mg dos veces al día, durante un período de 2 a 5 días o hasta la desaparición de la fiebre. Aunque la enfermedad es generalmente leve y autolimitada, lo que significa que puede resolverse sin tratamiento específico, en ocasiones los síntomas pueden ser más graves, lo que requiere hospitalización. En general, el tratamiento adecuado acelera la resolución de los síntomas y previene complicaciones mayores.
El control de la rickettsiosis por Rickettsia akari implica principalmente la eliminación de los roedores de los hábitats humanos y la aplicación de insecticidas para controlar la población de ácaros vectores. Dado que la enfermedad está fuertemente asociada con condiciones de hacinamiento y viviendas infestadas de roedores, las estrategias de control deben centrarse en mejorar las condiciones sanitarias y de vivienda, así como en la eliminación de los vectores que facilitan la transmisión del patógeno.

Fuente y lecturas recomendadas:
- Vyas NS et al. Investigating the histopathological findings and immunolocalization of rickettsialpox infection in skin biopsies: a case series and review of the literature. J Cutan Pathol. 2020;47:451. [PMID: 31955452]